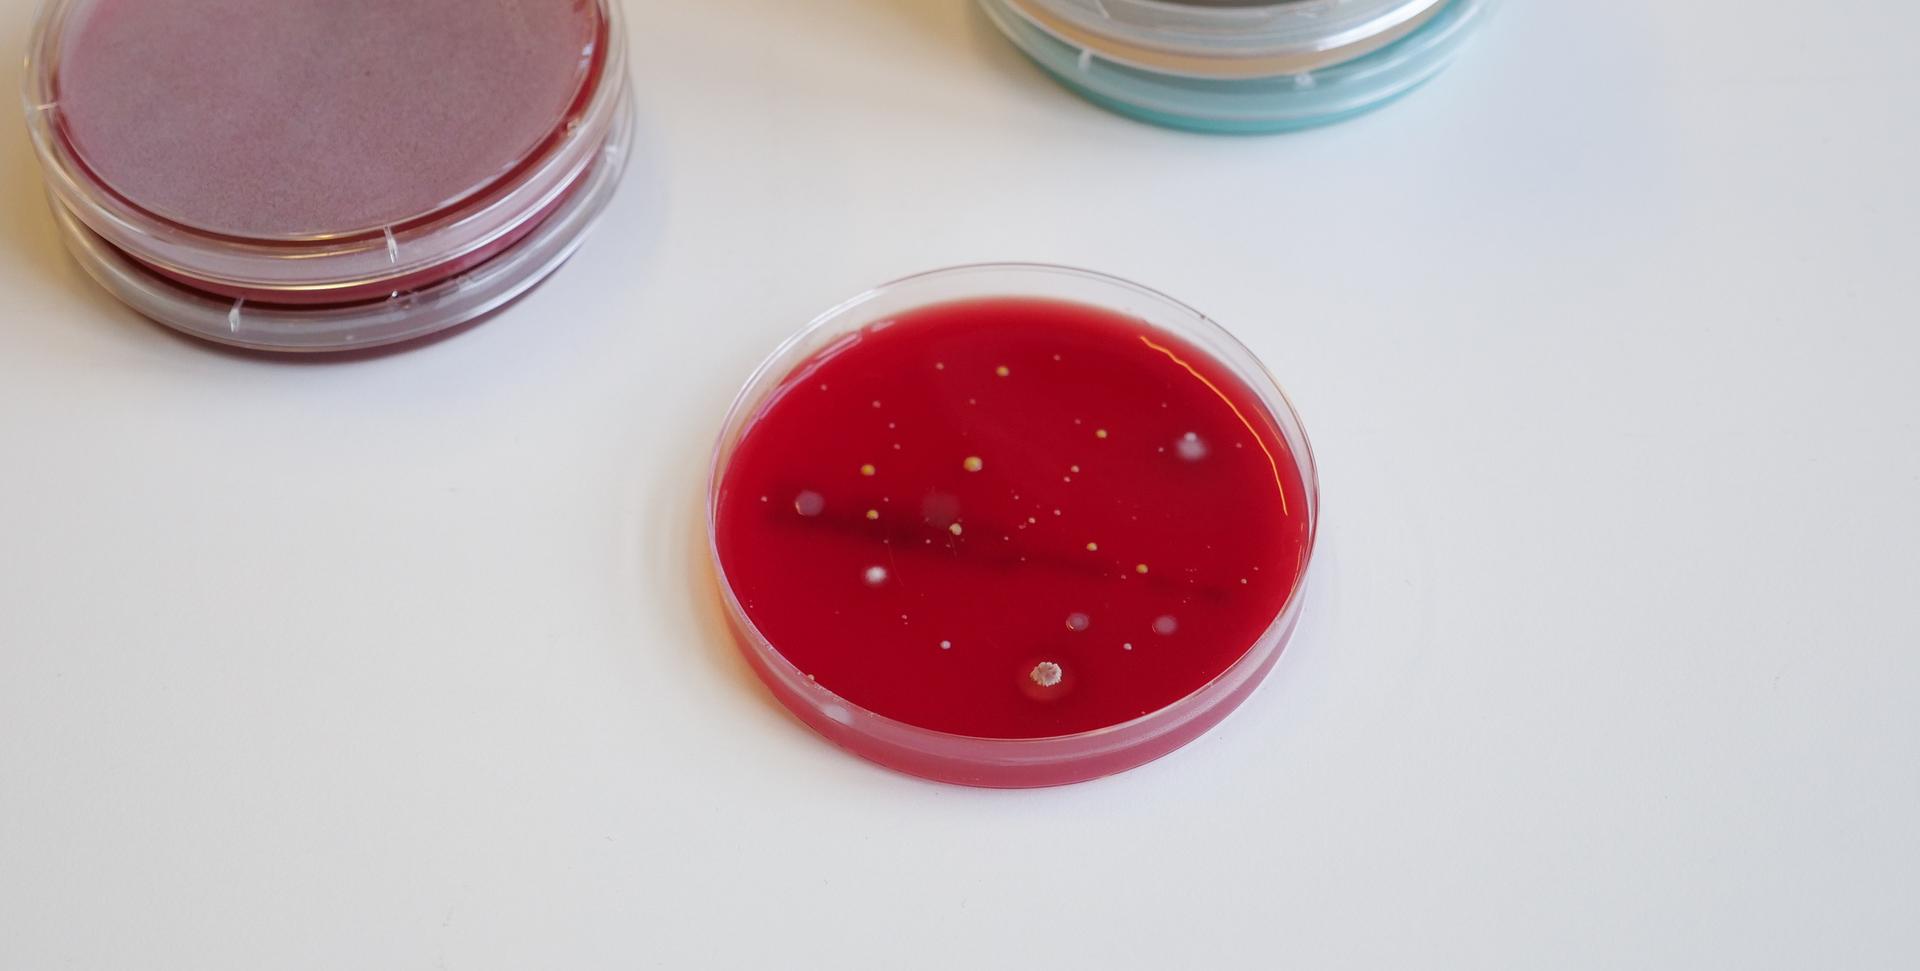
Bakterier på petriskål

Meieriprodukter du kan ha i beredskapslageret
I myndighetenes råd om beredskapslager anbefales en rekke matvarer og utstyr, for å sikre at man kan overleve på egenhånd i minst én uke ved en eventuell krise. Også meieriprodukter kan være en del av ditt beredskapslager.
Alle anbefales å ha et beredskapslager hjemme, i tilfelle en krise skulle inntreffe og tilgjengeligheten på mat reduseres. Det kan være krig, men det kan også være uforutsette naturkatastrofer, strømbrudd, tekniske problemer, pandemi eller terror.
Uansett hva det måtte være, er det smart å være forberedt – også på det man tenker aldri kommer til å skje.
Myndighetene har selv kommet med tips til anbefalte matvarer og andre beredskapsartikler det kan være greit å ha. Felles for matvarene er at de skal ha lang holdbarhet og kunne oppbevares i romtemperatur.
Kan jeg ha meieriprodukter i beredskapslageret mitt?
Ja, du kan ha enkelte meieriprodukter i beredskapslageret ditt.
Det er smart å inkludere meieriprodukter blant matvarene du lagrer, da man i en eventuell krisesituasjon også bør ha mat med mye næring tilgjengelig. Fordi meieriprodukter er næringstette matvarer, er de gode å ha i krisetider, der det kan være et mål å få i seg så mye næring som mulig fra så lite mat som mulig. Selv om myndighetene tar sikte på at man trenger å være selvforsynt i én uke, betyr ikke det nødvendigvis at man kan dra på butikken på dag åtte.
Det er riktignok ikke alle meieriprodukter som holder seg like godt i romtemperatur, noe man må ta i betraktning. De fleste meieriprodukter krever lagring i kjøleskap, særlig etter åpning, mens noen produkter også kan klare seg i romtemperatur.
For vanlig hvit melk vil holdbarheten variere mye. Den melken de fleste kjøper er varmebehandlet på lav temperatur og har en holdbarhet på omlag 20 dager. Men, det finnes også melk med lengre holdbarhet, som har vært varmebehandlet ved høyere temperatur, såkalt UHT-behandlet melk.
Hvilke meieriprodukter kan man ha i beredskapslageret?
Det er flere meieriprodukter man kan ha i beredskapslageret sitt, som både har god holdbarhet, kan stå i romtemperatur og som er rik på næringsstoffer. Mens noen meieriprodukter bare kan stå i romtemperatur uåpnet, finnes det også meieriprodukter som kan stå i romtemperatur før åpning.
I utgangspunktet skal man i et beredskapslager ta høyde for verst tenkelig scenario, der man ikke har strømtilgang, men i enkelte krisesituasjoner vil man likevel ha tilgang til både strøm og kjøleskap.
Tørrmelk
Tørrmelk, også kalt melkepulver, er et godt alternativ til den vanlig hvite melken vi har i kjøleskapet. Den blir nemlig omtrent som vanlig melk igjen hvis man tilsetter vann. Er tørrmelken laget av skummet melk, har den svært lang holdbarhet, ofte 3-4 år dersom den er uåpnet og oppbevart på et tørt sted som holder lavere temperatur enn 20 °C. Åpnet pakke bør brukes innen 2-3 uker, og lagres tørt og kjølig.
Hvor kan man kjøpe tørrmelk?
Tørrmelk er som regel ikke tilgjengelig i vanlige dagligvarebutikker i små pakker, da det ofte leveres til industrien i store kvanta. Du kan kjøpe tørrmelk i nettbutikker som spesialiserer seg på turmat eller meieriprodukter. Internasjonale dagligvarebutikker i større byer kan også ha tørrmelk i sitt sortiment.
Smøreost
Smøreost et smart pålegg å ha i beredskapslageret. Den kan ligge uåpnet i romtemperatur i åtte uker, og den er perfekt å ha som pålegg på for eksempel knekkebrød, som også anbefales i et beredskapslager.
Kondensert melk
Kondensert melk er ikke noe mange bruker til hverdags, men den kan være fin å ha i beredskapslageret da produktet er næringsrikt. Usukret kondensert melk er kort fortalt helmelk, der en del av vanninnholdet er fjernet ved vakuuminndamping slik at melkens kvalitet eller næringsverdi ikke endres nevneverdig. Den er god å bruke i bakst, og holdbarheten er gjerne opp til flere år. Etter åpning bør produktet oppbevares kjølig.
Kondensert melk kommer på hermetikkboks og er tilgjengelig i mange dagligvarebutikker og via netthandel.
UHT-melk
UHT-melk omfatter flere typer melk, og har lang holdbarhet ved kjøling. Dersom denne melken i tillegg er pakket sterilt, vil den dessuten kunne lagres i romtemperatur. Dette er for eksempel vanlig i flere andre land i verden, og gjelder også for enkelte produkter i Norge. Spør gjerne produsentene direkte om hvilke produkter dette vil gjelde fra deres sortiment.
Eksempler på UHT-melk er:
Laktosefri melk har en holdbarhet på 3-4 måneder. Denne melken kan stå i romtemperatur så lenge den er uåpnet, selv om vi er vant til å drikke den kald. Men, husk å drikk melken før utløpsdato – og fyll opp lageret på nytt!
Langtidsholdbar melk som er aseptisk (sterilt) pakket, kan som regel oppbevares i romtemperatur i fire til seks måneder, frem til den åpnes. Da er holdbarheten cirka én uke i kjøleskap.
Les på pakkene for å finne ut hva som gjelder for hvert produkt.
Ha en rotasjonsplan
Siden man aldri vet om og evt. når et beredskapslager vil bli nødvendig er det lurt å ha en plan for jevnlig å bruke og erstatte produktene som finnes i lageret. Bruk opp matvarer som nærmer seg utløpsdatoen, og erstatt dem med nye produkter med lengre holdbarhet. Et smart prinsipp er derfor å ha en systematisk rotasjon av forsyningene, enten det gjelder vann, tørrvarer eller hermetikk.
Myndighetenes beredskapsliste
(Eksempler på hva man kan ha i hus for å klare seg selv i syv dager.)
- 20 liter vann per person.
- Ha ekstra matvarer med lang holdbarhet, som kan lagres i romtemperatur. Gode eksempler er knekkebrød, havregryn, hermetiske linser og bønner, påleggshermetikk, energibarer, tørket frukt, sjokolade, honning, kjeks og nøtter.
- Du kan også lagre langtidsholdbar mat som krever enkel varmebehandling, som pasta, ris, posesuppe, mel, middagshermetikk og frysetørret mat.
- Grill, kokeapparat eller stormkjøkken.
- Varme klær, pledd, dyner og soveposer.
- Fyrstikker og stearinlys.
- Ved hvis du har vedovn eller peis.
- Gass- eller parafinovn som er beregnet for innendørs bruk er et alternativ til vedfyring.
- Avtale om overnatting hvis du ikke har alternativ oppvarming.
- Lommelykter eller hodelykter som går på batterier, sveiv eller solceller.
- DAB-radio som går på batterier, sveiv eller solceller.
- Legemidler og førstehjelpsutstyr.
- Jodtabletter (gjelder barn og voksne under 40 år, gravide og ammende).
- Hygieneartikler som våtservietter, håndsprit, bleier, dopapir og menstruasjonsprodukter.
- Batterier og ladet batteribank.
- Litt kontanter og flere betalingskort.
- Eventuelt mat og vann til kjæledyr.
- Liste på papir med viktige telefonnummer som for eksempel nødnummer, legevakt, veterinær, familie, venner og naboer.
Kilde: Direktoratet for samfunnssikkerhet og beredskap, Sikker hverdag